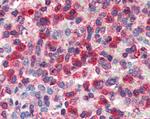
G6PD Antibody in Immunohistochemistry (Paraffin) (IHC (P))

Search
Invitrogen
G6PD Polyclonal Antibody
{{$productOrderCtrl.translations['antibody.pdp.commerceCard.promotion.promotions']}}
{{$productOrderCtrl.translations['antibody.pdp.commerceCard.promotion.viewpromo']}}
{{$productOrderCtrl.translations['antibody.pdp.commerceCard.promotion.promocode']}}: {{promo.promoCode}} {{promo.promoTitle}} {{promo.promoDescription}}. {{$productOrderCtrl.translations['antibody.pdp.commerceCard.promotion.learnmore']}}

Please note: We are reviewing Western blot images included in the antibody testing data in our catalog, including those provided by third parties. Unless expressly labeled or annotated as “raw-unedited”, Western blot images included in the antibody testing data in our catalog may have been edited, optimized or otherwise adjusted for presentation.
产品信息
PA5-18734
种属反应
已发表种属
宿主/亚型
分类
类型
抗原
偶联物
形式
浓度
规格
纯化类型
保存液
内含物
保存条件
运输条件
RRID
产品详细信息
This antibody is predicted to react with canine, mouse and rat based on sequence homology.
This antibody is tested in Peptide ELISA: antibody detection limit dilution 32,000.
靶标信息
This gene encodes glucose-6-phosphate dehydrogenase. This protein is a cytosolic enzyme encoded by a housekeeping X-linked gene whose main function is to produce NADPH, a key electron donor in the defense against oxidizing agents and in reductive biosynthetic reactions. G6PD is remarkable for its genetic diversity. Many variants of G6PD, mostly produced from missense mutations, have been described with wide ranging levels of enzyme activity and associated clinical symptoms. G6PD deficiency may cause neonatal jaundice, acute hemolysis, or severe chronic non-spherocytic hemolytic anemia. Two transcript variants encoding different isoforms have been found for this gene.
仅用于科研。不用于诊断过程。未经明确授权不得转售。




